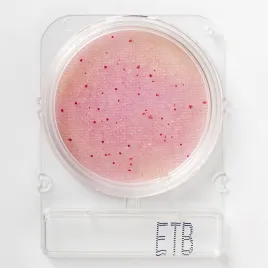

Современные решения для микробиологического анализа: готовые подложки для быстрого и точного определения микроорганизмов
В современной микробиологии, где скорость и точность играют ключевую роль, все большую популярность приобретают готовые к использованию подложки с сухой питательной средой. Эти инновационные тест-системы значительно упрощают и ускоряют процесс исследования, избавляя от необходимости трудоемкого приготовления сред, автоклавирования и разлива агаров. Они идеально подходят для анализа широкого спектра образцов: от пищевых продуктов и воды до смывов с поверхностей, а также фармацевтической и косметической продукции.
Как это работает?
Принцип действия этих подложек прост и эффективен. В их состав входит лиофилизированная питательная среда, обогащенная селективными компонентами и индикаторами. После внесения образца (обычно 1 мл пробы) жидкость благодаря капиллярному эффекту равномерно распределяется по всей поверхности подложки. Далее следует инкубация при температуре, указанной в инструкции. Оценка результатов осуществляется путем подсчета и визуального анализа колоний, цвет которых позволяет с высокой точностью идентифицировать присутствующие микроорганизмы.
Преимущества использования:
Экономия времени и ресурсов: Отсутствие необходимости в подготовке сред существенно сокращает трудозатраты и потребление энергии.
- Минимизация риска контаминации: Специальная конструкция с закрывающейся крышкой надежно защищает от внешнего загрязнения.
- Длительный срок хранения: В зависимости от типа подложек, их срок годности может достигать от 12 месяцев до 3 лет при соблюдении рекомендованных условий хранения (часто при комнатной температуре или в холодильнике).
- Удобство и компактность: Подложки легко штабелируются, что экономит ценное пространство как в термостате, так и при хранении.
- Высокая точность результатов: Использование хромогенных субстратов обеспечивает наглядную идентификацию микроорганизмов по характерному цвету колоний.
Широкий спектр применения и разнообразие сред
Линейка продуктов Compact Dry предлагает обширный аналитический потенциал, охватывая до 15 различных параметров. Эти подложки универсальны и подходят для анализа как твердых, так и жидких проб.
Линейка продуктов HiPetriSlim™ ( HiMedia Laboratories Pvt. Ltd. (Индия)— это готовые питательные среды в компактном формате чашек Петри.
Где применяются?
Подложки находят широкое применение в лабораториях пищевых предприятий, предприятий общественного питания, производственных и ветеринарных лабораториях, учреждениях контроля качества воды, а также в научно-исследовательских центрах. Они незаменимы при анализе сырья, готовой продукции, воды, смывов с оборудования, инвентаря, рук персонала и объектов окружающей среды.
Важные аспекты при использовании:
- Для получения достоверных результатов крайне важно строго следовать утвержденным методикам (ГОСТ, ISO, внутренние стандарты предприятия).
- После использования подложки могут содержать жизнеспособные микроорганизмы, поэтому их утилизация должна проводиться в соответствии с санитарными нормами.
- При выборе подложек необходимо учитывать специфику определяемых микроорганизмов и рекомендованные условия инкубации, указанные в инструкции.
Вся продукция соответствует международным стандартам качества, включая ISO 9001, ISO 13485, WHO-GMP, и зарегистрирована в FDA. Сухие среды для микробиологического контроля в фармацевтической отрасли отвечают требованиям ведущих фармакопей мира, таких как USP, BP, Ph. Eur., JP, IP.
- Подложки общее микробное число - Compact Dry TС Соответствует правилам Управления по санитарному надзору за качеством пищевых продуктов и медикаментов (FDA); продукты питания (...4 шт.
- Подложки общее микробное число - Compact Dry TCR (быстрый тест) Это готовая к использованию среда для подсчета общего количества жизнеспособных микроорганизмов в твердых или жидких образцах...4 шт.
- Подложки кишечная палочка и колиформные бактерии - Compact Dry EC Готовая к использованию хромогенная среда для идентификации кишечной палочки и бактерий группы колиформ. Она содержит 2...4 шт.
- Подложки колиформные и фекальные колиформные бактерии - Compact Dry CF Готовая к использованию сухая хромогенная среда для идентификации бактерий колиформной группы. Благодаря хромогенным...4 шт.
- Подложки плесень и дрожжи - Compact Dry YM Готовая к использованию сухая хромогенная среда для идентификации плесневых и дрожжевых грибов. Она содержит хромогенный ферментный субстрат X-...4 шт.
- Подложки плесень и дрожжи - Compact Dry YMR Готовая к использованию сухая хромогенная среда для быстрой идентификации плесневых и дрожжевых грибов. Она содержит хромогенный ферментный...4 шт.
- Подложки сальмонелла - Compact Dry SL Тест на присудствие/отсудствие Как в пищевых продуктах, так и в образцах окружающей среды анализ на сальмонеллу является обязательным....4 шт.
- Подложки золотистый стафилококк - Compact Dry X-SA Хромогенная готовая к использованию среда для идентификации Staphylococcus aureus . Большое количество золотистого стафилококка...4 шт.
- Подложки бациллы эхиноцереус - Compact Dry X-BC Бациллы Эхиноцереус (Bacillus cereus) — грамположительная аэробная спорообразующая бактерия, которая процветает в почве, овощах и...4 шт.
- Подложки парагемолитический вибрион - Compact Dry VP Парагемолитический Вибрион (Vibrio parahaemolyticus) — это патоген, который может развиваться в соленой воде и заражать все морепродукты...4 шт.
- Подложки энтеробактерии - Compact Dry ETB Готовая к использованию сухая хромогенная среда, содержащая глюкозу, для идентификации семейства Энтеробактерии (Enterobacteriaceae)....4 шт.
- Подложки энтерококки - Compact Dry ETC Готовая к использованию сухая хромогенная готовая среда для идентификации семейства - Энтерококки (Enterococcus). Энтерококки...4 шт.
- Подложки синегнойная палочка - Compact Dry PА Готовая к использованию сухая хромогенная среда для идентификации Синегнойная палочка (Pseudomonas Aeruginosa). Синегнойная палочка (Pseudomonas...4 шт.
- Подложки листерия - Compact Dry LS Готовая к использованию сухая хромогенная среда для идентификации видов Листерии (Listeria Monocytogenes ve Listeria spp.) Виды Листерии встречаются в...4 шт.
- Подложки гетеротрофных бактерий в питьевой воде - Compact Dry AQ Готовая к использованию сухая хромогенная готовая среда для выявления гетеротрофных бактерий. Побложка обеспечивает...4 шт.
- Подложки листерия моноцитогенес - Compact Dry LM Готовая к использованию, обезвоженная хромогенная питательная среда для подсчета и обнаружения Листерия Моноцитогенес (Listeria...4 шт.
- Предназначено для определения общего количества аэробных микроорганизмов (ОКАМ).Контроль качества и санитарно-бактериологического анализа следующих объектов:пищевые продукты;молочная продукция;...50 шт. HPS001-50PT
- Предназначено для определения общего количества аэробных микроорганизмов (ОКАМ).Контроль качества и санитарно-бактериологического анализа следующих объектов:пищевые продукты;молочная продукция;...100 шт. HPS001-100PT
- Контроль качества и санитарно-бактериологического анализа следующих объектов:пищевые продукты;молочная продукция;питьевая вода;сточные воды.Температура хранения: от 2 до 8 °C.50 шт. HPS002-50PT
- Контроль качества и санитарно-бактериологического анализа следующих объектов:пищевые продукты;молочная продукция;питьевая вода;сточные воды.Температура хранения: от 2 до 8 °C.100 шт. HPS002-100PT
- Применяется для селективного подсчета Escherichia coli и колиформ в пищевой и молочной промышленности.Температура хранения: от 2 до 8°C.50 шт. HPS003-50PT
- Применяется для селективного подсчета Escherichia coli и колиформ в пищевой и молочной промышленности, питьвой воде.Температура хранения: от 2 до 8°C.100 шт. HPS003-100PT
- Применяется для селективного подсчета Escherichia coli Escherichia coli в пищевой и молочной промышленности, питьвой воде.Температура хранения: от 2 до 8°C.50 шт. HPS004-50PT
- Применяется для селективного подсчета Escherichia coli Escherichia coli в пищевой и молочной промышленности, питьвой воде.Температура хранения: от 2 до 8°C.100 шт. HPS004-100PT
- Специализированная среда для селективного выделения и подсчета золотистого стафилококка в микробиологических исследованиях.Используется в санитарно-бактериологическом контроле пищевых продуктов,...50 шт. HPS005-50PT
- Специализированная среда для селективного выделения и подсчета золотистого стафилококка в микробиологических исследованиях.Используется в санитарно-бактериологическом контроле пищевых продуктов,...100 шт. HPS005-100PT
- Специализированная среда для микробиологического анализа и контроля санитарных параметров.Температура хранения: от 2 до 8°C.50 шт. HPS006-50PT
- Специализированная среда для микробиологического анализа и контроля санитарных параметров.Температура хранения: от 2 до 8°C.100 шт. HPS006-100PT
- Предназначена для селективного выделения и дифференциации колиформных бактерий и Escherichia coli в пробах воды. Хромогенные субстраты позволяют проводить идентификацию микроорганизмов по цвету...50 шт. HPS007-50PT
- Предназначена для селективного выделения и дифференциации колиформных бактерий и Escherichia coli в пробах воды. Хромогенные субстраты позволяют проводить идентификацию микроорганизмов по цвету...100 шт. HPS007-100PT
- Предназначены для селективного выделения и подсчета бактерий группы кишечной палочки (энтеробактерий) в различных пробах. Компактный формат чашек Slim позволяет оптимизировать пространство в...50 шт. HPS008-50PT
- Предназначены для селективного выделения и подсчета бактерий группы кишечной палочки (энтеробактерий) в различных пробах. Компактный формат чашек Slim позволяет оптимизировать пространство в...100 шт. HPS008-100PT
- Специализированная хромогенная среда для быстрого обнаружения Salmonella spp.Температура хранения: 2–8 °C.50 шт. HPS009-50PT
- Специализированная хромогенная среда для быстрого обнаружения Salmonella spp.Температура хранения: 2–8 °C.100 шт. HPS009-100PT
- Предназначены для селективного выделения и количественного определения вибрионов в микробиологических исследованиях.50 шт. HPS010-50PT
- Предназначены для селективного выделения и количественного определения вибрионов в микробиологических исследованиях.100 шт. HPS010-100PT
- Предназначено для определения общего количества аэробных микроорганизмов (ОКАМ) и оценки: санитарного качества продуктов питания и воды; эффективности процессов стерилизации и пастеризации;свежести...50 шт. HPS011-50PT
- Предназначено для определения общего количества аэробных микроорганизмов (ОКАМ) и оценки: санитарного качества продуктов питания и воды; эффективности процессов стерилизации и пастеризации;свежести...100 шт. HPS011-100PT